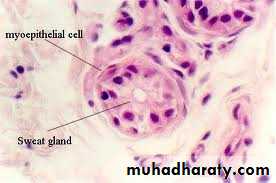

بسم الله الرحمن الرحيم
Prof. Dr. Huda Al-khateeb
Head of Histology Section/Dept. of AnatomyHead of Quality Assurance & Academic Performance
College of Medicine/Univ. of Baghdad
SKIN
To study the histology of skin appendages and their functionsobjectives
Hair is an elongated keratinized structure
derived from invaginations of the epidermal epithelium called
hair follicles.
All skin has at least minimal hair except that of the palms, soles, lips, glans penis, clitoris, and labia minora.
Hair has root (within the skin) and shaft (outside the skin).
Hair
Hairs grow discontinuously, with periods of growth followed by periods of rest (peroid of growth depends on area of the body).
In the scalp, growth periods (anagen) may last for several years, whereas the periods of follicle regression (catagen) and inactivity (telogen) may together last only 3 to 4 months.
Hair growth on the face and pubis is strongly influenced by sex hormones, especially androgens.
Hairgrowth
Hirsutism – (Cushing syndrome)
Hair follicle
Hair follicle wall
(1)Connective tissue sheath(2) Glassy membrane
(3) External (outer)root sheath
(4)Internal (inner) root sheath
Hair
(1) Cuticle (2) Cortex (3) Medulla
Hair follicle
During anagen the hair follicle has a terminal dilatation called a hair bulb.
A dermal papilla inserts into the base of the hair bulb and contains a capillary network required to sustain the hair follicle.Loss of this blood flow results in death of the follicle.
Hair bulb
Allopecia and Allopecia Areata
A small bundle of smooth muscle fibers that run from the connective tissue sheath of hair follicle to the dermal papillary layer .
Contraction of these muscles pulls the hair shafts to a more erect position, usually when it is cold to produce tiny bumps on the skin surface ("goose bumps").
Arrector pili muscle
Nails
hard, flexible plates of keratin on the dorsal surface of each distal phalanx.The proximal part of the nail is the nail root and is covered by the proximal skin fold which is thin and lacks both hair and glands. The epidermal stratum corneum extending from the proximal nail fold forms the cuticle, or eponychium.
The keratinized nail plate is bound to a bed of epidermis called the nail bed, which contains only the basal and spinous layers.
The nail plate extends from the nail root.
The nail plate continues growth and pushes distally over the nail bed (which makes no contribution to the plate) at about 3 mm/month for fingernails and 1 mm/month for toenails.The distal end of the plate becomes free of the nail bed at the epidermal fold called the hyponychium and is worn away or cut off.
Nails
paronychia
Sebaceous glands are embedded in the dermis over most of the body surface, except the thick skin of the palms and soles.
Sebaceous glands are branched acinar glands with several acini converging at a short duct which usually empties into the upper portion of a hair follicle.
Sebaceous Glands
The acini consist of a basal layer of undifferentiated flattened epithelial cells on the basal lamina. These cells proliferate and are displaced toward the middle of the acinus, undergoing terminal differentiation as distinctly large, lipid-producing sebocytes.
Sebaceous Glands
The cytoplasm of Sebocytes is filled with small fat droplets. Their nuclei shrink and undergo autophagy along with other organelles and near the duct the cells disintegrate and release the lipids via holocrine secretion. The product of this process is sebum, which is gradually moved to the surface of the skin along the hair follicle.
Sebaceous Glands
Sebum is a complex mixture of lipids that includes wax esters, squalene, cholesterol and triglycerides which are hydrolyzed by bacterial enzymes after secretion.
Secretion from sebaceous glands greatly increases at puberty, stimulated primarily by testosterone in men and by ovarian and adrenal androgens in women.
Specific functions of sebum appear to include helping maintain the stratum corneum and hair, as well as exerting weak antibacterial and antifungal properties on the skin surface.
Sebaceous Glands
The flow of sebum is continuous, and a disturbance in the normal secretion and flow of sebum is one of the reasons for the development of acne, a chronic inflammation of obstructed sebaceous glands common during and after puberty.
MEDICAL APPLICATION
Sweat glands are epithelial derivatives embedded in the dermis.
There are 2 types:Eccrine sweat glands
apocrine sweat glands
* have different distributions, functions, and structural details
Sweat Glands
* Eccrine sweat glands are widely distributed in the skin and are most numerous and most well developed on the palm of the hand and sole of the foot.
* Sweat gland is a simple coiled tubular gland.
* It has a rule in body temperature regulation.
* It is innervated by cholinergic nerves.
Eccrine sweat glands
Secretory part: (3 types of cells)
1.Clear cells (basal) – secret NaCl and water ( sweat)2.Dark cells (luminal) – secret bacricidal substances
3.Myoepithelial cells (peripheral)- contraction helps discharge of secretion
:Duct
Double layer s of cuboidal epithelium-reabsorb NaCl and water (under influence of aldosterone)
Eccrine sweat glands
The cells of the secretory part has lightly stained cytoplasm as compared to that of ducts
Sweat pores- on surface of epidermis
After its release on the surface of the skin sweat evaporates, cooling the skin. Besides its important cooling role, sweat glands also function as an excretory organ, eliminating small amounts of nitrogenous waste and excess salts.
(1)Apocrine sweat glands are found in axillary and perineal skin.
(2)Their development (but not functional activity) depends onsex hormones and is not complete until puberty.
(3)Their secretory acini are larger than that of eccrine sweat glands and contain 2-3 layers of myoepithelial cells
(4) Their ducts opens to the hair follicle
(5)Apocrine sweat glands are innervated by adrenergic nerve endings, whereas eccrine sweat glands receive cholinergic fibers
Apocrine sweat glands
The secretory portions consist of simple cuboidal, eosinophilic cells with numerous apical secretory granules that undergo exocytosis. Thus the glands are misnamed: their cells show merocrine, not apocrine, secretion.
The wall of the ducts is similar to that of the eccrine glands.
..Apocrine sweat glands
The slightly viscous secretion is initially odorless but may acquire a distinctive body odor as a result of bacterial activity.
Apocrine sweat glands